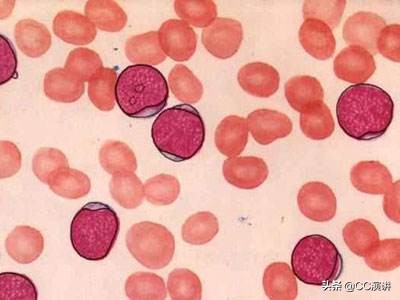
白血病不是不治之症单倍体移植如何破解白血病难题?

骨髓库再大,找到合适供体的概率仍太小,白血病因此令人生畏。
北京大学人民医院血液科主任黄晓*用军**10年实践证明,单倍体移植能行!
父母兄弟、叔舅姨姑,都可以是供体,“北京方案”赢得世界尊重。
“常识是一个时代对某些问题的偏见,而创新就是挑战常识的过程。”
正是秉持这个信念,黄晓军带领团队解决了全球未曾解决的医学难题!

和【CC演讲】一起,来听黄晓军如何破解这一世界级的医学难题——白血病。
白血病真是不治之症吗?
我和我的团队,通过建立发展和完善形成了一个造血干细胞移植治疗血液恶性疾病的一个新型体系。我非常荣幸非常骄傲地告诉大家就是这个方案,现在已经成为国际治疗血液恶性肿瘤里的一个主流的方案,并且这个方案推动了这个行业的发展。

根据2014年的数据,北京大学人民医院已经成为全球最大的异基因造血干细胞移植中心。同时,也是造血干细胞移植疗效最好的单位之一。所以我感到非常荣幸和骄傲,那么我下面要讲的故事就是北京方案的故事。

谈到白血病呢?大家一点都不陌生,我相信很多人会认为白血病那就是不治之症,但是白血病真的是不治之症吗?它不是的!其实白血病不管是你通过药物治疗,还是造血干细胞移植治疗,其实都有可能把这个病治好。这是一个科普的东西,但是造血干细胞移植目前仍然是许许多多的疾病最有效的治疗方式之一。

那么造血干细胞移植就像这个图一样的,就是我们把正常了的造血干细胞取出来,把它回输给经过放化疗我们把它叫做预处理的这个病人,然后这个输进去的干细胞就会在病人身上重建造血和免疫,那这样就把病人的疾病给治好了。这么一个过程就是造血干细胞移植,那造血干细胞移植的前提是,首先你必须有正常的造血干细胞来源,它既是它的前提,事实上它也是多少年来影响造血干细胞移植发展的一个困局。

当然按照传统的理论要进行造血干细胞移植,必须供者的配型和受者的配型要完全百分之百的相同,所以应该说只能从同胞姐妹兄弟姐妹之间找配型,一般人能进行干细胞移植的概率只有25%的机会,再加上中国基本上是一个独生子女的家庭,所以这种干细胞的来源会变得越来越少,因此我们可以看到在中国也在全世界都有非血缘供者的来源提供骨髓,那非血缘供者的确是解决了一部分问题。但是由于每个个体的配型如果没有血缘关系它是会差得很远的,或者说它是一个小概率事件。

比如说我们中国的骨髓库现在已经有200万的志愿者,但是即便是这么大的志愿者群体,其实你从中找到供者的可能性还是非常低的。
那么根据我们中华骨髓库红十字会的数据到2012年的数据,大概只有11%的人能够从中找到供者,所以要解决供者来源的问题最好就是单倍型。这个单倍型我们简单的说就是配型一半相同就够了,这就叫单倍型。

所以从这个规律来说我们可以很简单去讲,就父母和孩子,孩子跟父母一定是单倍型,或者我们也把它叫做配型不合。但是单倍型是一个有具有非常很好的前途解决供者来源的一个途径,但是问题就像我们下面展示的数据,它的排斥率就是输进去它不长,抗宿主病,输进的细胞不仅对肿瘤有*伤杀**作用,在对正常来源有*伤杀**作用。最后它的总的生存率跟同胞全合来比只有它的三分之一,所以单倍型既是研究的热点但是很多的时候就成为一个禁区,那国外实际上也是一样。

锁定G—CSF,暂时管控T细胞的功能
在上世纪90年代已经开始在做这个尝试,那么我就在想啊,我之所以这里面输进去的会出现抗宿主病,那可能最主要的是T细胞,这个T细胞它有什么作用呢?它能抗肿瘤但也能抗宿主,就是抗病人本身也能抗感染,所以老外的想法呢?就是我把T细胞去掉,去掉之后那么它就不会出现抗宿主本身的问题。但是问题是这个带来一个什么问题?带来了感染、排斥复发升高,所以虽然有一部分进展,但是这个方案并没有得到非常好的推广和普及。
我们其实在之前也尝试了老外的一个方案,因为中国人的一个习惯,西医毕竟从西方传过来的,所以我们还是会比较相信西方的,那么那个时候我们在90年代末也尝试了一种去T的方式,但是效果不是很好,所以我们就在想如既然T细胞去掉了,是能解决抗宿主病的问题,但是它并不能解决肿瘤的问题,并不能解决感染的问题,那我们有没有什么用中方文化的思路去解决它呢?我们能不能把这个T细胞的功能暂时管控起来,让它早期不产生抗宿主病,然后把它输进去以后,等过一段时间它们适应了,我们再把T细胞功能放出来,然后让它慢慢去抗肿瘤慢慢去抗感染,所以我们锁定了G-CSF。当然今天来讲这个故事已经过去了很久。

G-CSF我们对它的机子已经很清楚了,但是在十几年前的时候,其实我们只是一些简单的体外实验。我们并没有特别有信心的说它一定行,只是我们觉得它可能行,所以讲到这里我就必须讲一讲我和病人之间的故事。
在01年、02年和03年,其实2001年我们可能做了三例、四例,那2002年我们做得多一点,那开始做的时候就像我们选择了什么呢?选是复发的病人,这个病人大家可能知道白血病如果复发了,不马上做的话通常两三个月就不行了。所以我们选的我记得第一例非常清楚,他是一个做完自体移植以后复发的病人,那么各种药物都无效,所以这个时候,我就给他讲过了我说如果用药物治疗,我们也是在尽力,但是我估计是不行的。如果要解决问题最好做异体,但是他独生子女他没办法做异体,所以,他说他能不能考虑做父亲给他的,但是父亲给他的全世界都没有太多的经验,我觉得用G—CFS来诱导免疫耐受能行。
实际上病人当然会很积极,这个时候我们会沟通,但是真的他想做的时候我又开始犹豫,我跟他说我还真不一定敢做,我说我只是想它有用,但是不一定有用。所以我想彼此的真诚的沟通是非常重要的,那病人说:“黄大夫,我这个病开始前几年治也是你给我治的,我已经活了两年多了,这个复发了不做我也就没机会了,即便是不行了,我觉得你也积累了经验,所以你就大胆的去做吧!”

所以在他的鼓励下,所以我们就按照我们的方式去做了,当然我们很幸运我们也做成了最后。但实际上在这个过程中我受到了很大的震撼,因为病人对生命的渴望,对我的信任才使得我的勇气能够跨过这一步,但是如果他没有信任我,不让我跨过这一步,我可能永远停留在体外,我可能永远停留在动物实验,甚至有可能永远停留在想象之中。那这个病人后来因为我们老有接触,他是非常感谢我,他把我作为他当成他的救命恩人,但实际上我内心也一直非常想说的是,其实我个人觉得我应该感谢的是你!因为你用生命让我成就了我的创新之举,所以我还是想借着今天这个CC讲坛,想对支持我信任我们的所有的病人,表示衷心地感谢!